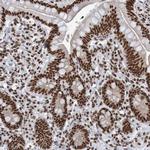
THRAP3 Antibody in Immunohistochemistry (Paraffin) (IHC (P))
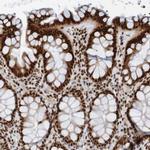
THRAP3 Antibody in Immunohistochemistry (IHC)

Search
Invitrogen
THRAP3 Polyclonal Antibody
{{$productOrderCtrl.translations['antibody.pdp.commerceCard.promotion.promotions']}}
{{$productOrderCtrl.translations['antibody.pdp.commerceCard.promotion.viewpromo']}}
{{$productOrderCtrl.translations['antibody.pdp.commerceCard.promotion.promocode']}}: {{promo.promoCode}} {{promo.promoTitle}} {{promo.promoDescription}}. {{$productOrderCtrl.translations['antibody.pdp.commerceCard.promotion.learnmore']}}
产品信息
PA5-52898
种属反应
宿主/亚型
分类
类型
抗原
偶联物
形式
浓度
规格
纯化类型
保存液
内含物
保存条件
运输条件
RRID
产品详细信息
Immunogen sequence: ETEEREESTT GFDKSRLGTK DFVGPSERGG GRARGTFQFR ARGRGWGRGN YSGNNNNNSN NDFQKRNREE EWDPEYTPKS KKYYLHDDRE GEGSDKWVSR GRGRGAFPRG RGRFMFRKSS TSPKWAHDKF S
Highest antigen sequence identity to the following orthologs: Mouse - 95%, Rat - 95%.
靶标信息
THRAP3 is a 955 amino acid novel nuclear receptor and a member of the Thyroid hormone receptor associated proteins with a LISH domain and no obvious known sequence motifs. THRAP3 is a 150 kDa subunit of the large multiprotein complex TRAP and is important in the maintenance of the fundamental structure of the fibrillar center and dense fibrillar component in the nucleolus. It is also known to play an important role in transcriptional coactivation. It is known to interact with DKC1, nop5/nap65 and fibrillarin. From the Northern blot analysis of several human tissues it was found that TRAP150 is ubiquitously expressed.
仅用于科研。不用于诊断过程。未经明确授权不得转售。
篇参考文献 (0)
生物信息学
蛋白别名: BCLAF1 and THRAP3 family member 2; Thyroid hormone receptor-associated protein 3; Thyroid hormone receptor-associated protein complex 150 kDa component; thyroid hormone receptor-associated protein, 150 kDa subunit; TR-associated protein, 150-kDa; Trap150
基因别名: BCLAF2; THRAP3; TRAP150
UniProt ID: (Human) Q9Y2W1
Entrez Gene ID: (Human) 9967